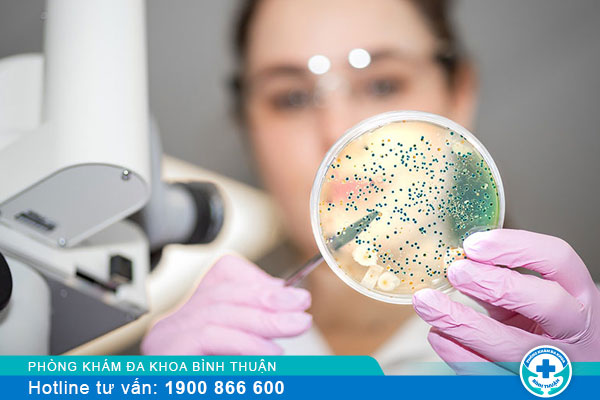

Nguyên nhân gặp hiện tượng tiểu buốt ra mủ ở nam
Hiện tượng tiểu buốt ra mủ ở nam giới gây ra nhiều tâm lý lo lắng và hoang mang không biết đây là dấu hiệu cảnh báo cho vấn đề bất thường nào ở vùng kín. Để tìm hiểu chính xác được nguyên nhân và mức độ nguy hiểm khi nam giới gặp phải hiện tượng này thì bạn cần chủ động tìm hiểu các thông tin được chia sẻ bên dưới.
NGUYÊN NHÂN BỆNH LÝ GÂY TIỂU BUỐT CÓ MỦ Ở NAM
Khi nhận thấy tình trạng tiểu buốt ra mồ ở nam giới thì phải chủ động nhanh chóng để tìm hiểu chính xác được nguyên nhân gây ra vấn đề. Theo các chuyên gia y tế thì có nhiều nguyên nhân bệnh lý khác nhau dẫn đến hiện tượng tiểu buốt có mủ và trong đó nguyên nhân phổ biến là:
Bệnh lậu
Có thể xem đây là một trong số các căn bệnh xã hội rất nguy hiểm, do vi khuẩn song cầu lậu gây ra và chủ yếu bệnh này lây nhiễm thông qua đường tình dục. Người bệnh sẽ xuất hiện các triệu chứng sau khoảng thời gian từ 2 đến 9 ngày kể từ khi song cầu lậu tấn công. Nam giới khi gặp hiện tượng sưng đỏ, có cảm giác đau buốt và có mủ đọng lại ở đầu dương vật khi tiểu tiện là dấu hiệu điển hình của bệnh lậu. Đây là căn bệnh cần sớm can thiệp và hỗ trợ được hỗ trợ điều trị để ngăn chặn các biến chứng nguy hiểm.
Viêm niệu đạo
Đa số nam giới bị viêm niệu đạo thường xuất phát từ nguyên nhân vệ sinh vùng kín không sạch sẽ, có các hoạt động tình dục không an toàn nên bị lây nhiễm các loại vi khuẩn, nấm. Phim niệu đạo khiến cho nam giới phải gặp tình trạng tiểu rắt, tiểu buốt, tiểu có mủ,... Đồng thời thì nam giới cũng gặp các khó khăn trong việc quan hệ tình dục do tình trạng dương vật tăng dịch tiết và đau nhức, thậm chí có thể bị chảy máu.
Viêm bàng quang
Một trong những nguyên nhân dẫn đến hiện tượng tiểu buốt ra mủ ở nam giới có thể là bệnh lý về đường tiết niệu như viêm bàng. Nguyên nhân của bệnh có thể là do bàng quang đã bị tấn công bởi nấm hay vi khuẩn, chủ yếu là vi khuẩn E.coli. Tình trạng bàng quang đã bị viêm nhiễm thì sẽ khiến cho người bệnh cảm thấy muốn đi tiểu thường xuyên và ra dịch mủ màu vàng xanh. Nếu như hiện tượng căng tức ở vùng bụng dưới và tiểu ra máu thì cần đến bệnh viện để kịp thời hỗ trợ ngay.
Viêm tuyến tiền liệt
Căn bệnh này cũng do nấm và vi khuẩn gây hại cũng như căn bệnh xảy ra ở với nam giới và độ tuổi trung niên. Các loại nấm cũng như vi khuẩn sẽ dễ dàng xâm nhập vào tuyến tiền liệt từ đó tấn công và phá hủy đi các tế bào tuyến tiền liệt. Như vậy sẽ rất có hại vì nam giới không thể hoàn thành nhiệm vụ bài tiết đủ hai bài mỗi ngày.

Viêm bể thận
Đi được xem là tình trạng bị bội nhiễm dẫn đến bể thận hậu phát trở thành nguyên nhân gây ra viêm mũi. Nam giới thì mắc phải căn bệnh này thường xảy ra hiện tượng tiểu buốt, tiểu khó và bên trong nước tiểu có thể có mùi.
Có thể thấy tình trạng tiểu buốt ra ngủ ở nam giới xuất phát với nhiều nguyên nhân khác nhau và trong số đó đa phần đều là những bệnh lý nguy hiểm. Hãy chọn cơ sở chất lượng và uy tín để mang lại kết quả chính xác và hiệu quả.
MỨC ĐỘ NGUY HIỂM KHI TIỂU BUỐT RA MỦ GIẢM ĐI
Thực tế cho thấy tình trạng nam giới gặp phải hiện tượng tiểu buốt có mũ cần và tình trạng đáng báo động về sức khỏe, phải đi thăm khám nam khoa để có được phương án điều trị. Việc không điều trị kịp thời thì tiểu buốt có thể dẫn đến một số hậu quả như sau:
♦ Nguy cơ vô sinh: Vô sinh đang trở là thành ảnh hưởng nghiêm trọng đến sức khỏe các cặp vợ chồng. Tiểu buốt Nếu diễn ra lâu ngày mà không điều trị có khả năng làm tăng nguy cơ bị vô sinh và hiếm muộn.
♦ Stress và đổi tính: Tình trạng tiểu buốt có mủ tác động tiêu cực đến tâm lý của người bệnh. Lúc này nam giới thường trang trạng thái khó chịu và cáu gắt tình trạng tiểu buốt có thể đi lặp đi lặp lại rất nhiều lần và vào cả ban đêm,... vẫn có thể xảy ra khiến nam giới mệt mỏi chán ăn,...

♦ Giảm ham muốn: Theo nhiều nghiên cứu khoa học thì sự liên kết giữa tiểu buốt với tần số quan hệ tình dục của họ. Đây là lý do dẫn đến việc nam giới giảm ham muốn, luôn cảm thấy bị mất tự tin và trong khi đó e ngại với tâm lý.
♦ Những hệ lụy khác: Ngoài những căn bệnh nguy hiểm được kể trên thì việc tiểu buốt ra mủ ở nam giới có thể cảnh báo việc mắc các triệu chứng như suy thận, sỏi bàng quang hay viêm túi tinh,...
Việc tiểu buốt ở nam giới có thể cảnh báo cho rất nhiều vấn đề sức khỏe nên cần chủ động đi thăm khám và có phương án điều trị sớm. Nam giới cần đặt điều kiện sức khỏe lên hàng đầu để tư vấn khách hàng.
ĐỊA CHỈ CHẤT LƯỢNG CHỮA TIỂU BUỐT CÓ MỦ Ở NAM
Nếu bạn đang phân vân chưa thể lựa chọn được một địa chỉ chất lượng và uy tín để khám và trị bệnh thì hãy đến Phòng Khám Đa Khoa Phú Thủy Phan Thiết có mặt 04 Nguyễn Gia Tú, Phú Thuỷ, Tp. Phan Thiết, Bình Thuận. Khi lựa chọn thành công cơ sở y tế chuyên khoa chất lượng thì nam giới có thể yên tâm bởi vì:
► Phòng khám sở hiểu cách bác sĩ với năng lực chuyên môn, giỏi kinh nghiệm vững vàng và đặc biệt là thái độ tận tâm với người bệnh.
► Phòng khám sở hiểu được đội ngũ tư vấn viên trực tuyến 24/7 để sẵn sàng tiếp nhận và đón hỗ trợ thông tin cho người bệnh.
► Các phương án thăm khám cũng như chữa trị bệnh tiểu buốt có mủ ở nam giới sẽ luôn nằm ở mức độ phù hợp. Những bệnh nhân đã từng điều trị tại đây đánh giá mức chi phí phù hợp.

► Mọi thông tin cá nhân của người bệnh luôn được phòng khám bảo mật và không tiết lộ ra bên ngoài để đảm bảo được tính chính xác.
► Chi phí để chi trả cho việc thăm khám cũng như lựa chọn điều trị tiểu buốt ở nam giới luôn nằm ở mức độ phức tạp.
Mọi ý kiến thắc mắc liên quan nếu cần hỗ trợ thì chị em hãy liên lạc ngay đến địa chỉ hotline 0252 7303 888 để được tư vấn cụ thể. Chị em không được chủ quan trước hiện tượng quan hệ rát vùng kín vì đây có thể là dấu hiệu cho thấy chị em đang gặp các vấn đề. Việc chủ động đi thăm khám sức khỏe phụ khoa và rất quan trọng nên chị em nên chú ý để chia sẻ thêm với người khác. Mọi ý kiến thắc mắc liên quan nếu bệnh nhân cần hỗ trợ chi tiết thì liên lạc đến hotline hay nhắn tin vào khung chat nhé.